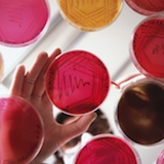

Procalcitonin: hope in the fight against antibiotic resistance?
We normally think of calcitonin as a hormone produced by the C‐cells of the thyroid, with the role of balancing parathyroid hormone in the conservation of calcium in the body. It's less widely known that calcitonin's precursor, procalcitonin, can be made by many cells, albeit at undetectable levels in healthy people. The discovery that procalcitonin is released into the blood in detectable amounts in response to severe bacterial infection was unexpected.[1] It may be related to the finding that hypocalcaemia is often present in critically ill patients and correlates with severity of illness, although the relationship is complicated.[2] Nevertheless, it opens a number of possibilities. Could procalcitonin be used as a diagnostic marker for serious infection? Any test or decision tool that helps to identify patients who do not need antibiotics could help to target antibiotic therapy more effectively.
To set this in context, it is worth thinking about the reasons for prescribing antibiotics for acute illness. Clearly the most important is to offset the risk of death and morbidity in clinical presentations that threaten this outcome. Pneumonia, once a dangerous condition with perhaps 50% mortality in otherwise healthy people in the pre‐antibiotic era, is now usually a routine episode of healthcare. Another reason is covering the possibility of serious bacterial infection: is the presentation a simple, self‐limiting disease, or is it the early stages of a very serious disease? It is often difficult to tell in the early stages.[3] Consequently, it is common for primary care clinicians to prescribe antibiotics for these ‘just‐in‐case’ presentations.
This ‘just‐in‐case’ scenario is one of the several contributors to over‐prescribing of antibiotics in primary care, especially acute respiratory infections (for which the greatest tonnage of antibiotics are prescribed). No amount of exhortation to reduce prescribing antibiotics based on the ‘lack of efficacy’ (supported by several Cochrane Reviews) or appeals to concern ourselves with antibiotic resistance can dissolve the real worry that our patient might be about to leave our primary‐care consultation and deteriorate rapidly in the next few hours. The textbook safety net is blood culture, but this is too slow, and insufficiently sensitive or specific.
This month sees the publication of a Cochrane Review evaluating the role of procalcitonin in guiding decisions about treating respiratory infections with antibiotics.[4] Its findings have some potentially far‐reaching implications, particularly for hospital settings, where most of the studies were conducted. Rather than relying on a gold standard to evaluate test accuracy, the review measures how many patients died following the decision to initiate or discontinue antibiotics based on levels of procalcitonin in the blood. The review tested the performance of procalcitonin in people at risk of serious infections, in intensive care, presenting to emergency departments, or in primary care – finding that antibiotic prescription decisions made on the basis of the test results did not increase the rate of mortality (about 5.8% with a procalcitonin algorithm versus 6.3% without) or morbidity. Crucially these results were achieved with a reduction in the amount of antibiotics used. In other words, when treatment decisions took account of procalcitonin levels antibiotics were better directed to the patients who needed them, with less waste to those who did not.
The findings of the review are highly significant. Safely reducing use of antibiotics means that fewer people are exposed to their side effects, but there is probably an even greater gain in view of the real worry about antibiotic resistance. This is no longer a theoretical, far‐off, ‘doomsday’ scenario: it is here. Every year, 25,000 patients die directly from antibiotic resistance in Europe alone.[5] And worse is to come. As resistance genes for the final last‐ditch antibiotics against infection promulgate via commensals throughout the community, so we are facing the dismantling of joint surgery, cardiac catheterisation, chemotherapy and other mainstays of modern medicine that need antibiotic cover, as we return to the dark ages of the pre‐antibiotic era. New antibiotics may only partially offset the threat of antibiotic resistance: long‐term strategies should force us to consider how to use the agents that we do have.
This review will help pave the way for the adoption of tests that can target antibiotic therapy to those who need it most, help reduce antibiotic resistance, and reassure patients that antibiotics are not always necessary for the plentiful acute respiratory infections that lead them to seek treatment.
Information
- DOI:
- https://doi.org/10.1002/14651858.ED000046Copy DOI
- Database:
-
- Cochrane Database of Systematic Reviews
- Published:
-
- 03 September 2012
- Copyright:
-
- Copyright © 2012 The Cochrane Collaboration. Published by John Wiley & Sons, Ltd.
Article Metrics
- Altmetric:
Topics
Authors
Declarations of interest
The authors have completed the Unified Competing Interest form at www.icmje.org/coi_disclosure.pdf (available upon request) and declares (1) that CDM's institution (Bond University, Australia) has received funding from the Australian National Health and Medical Research Council (NHMRC) on antibiotic resistance, and that CDM has received funding for travel by the Australian National Prescribing Service to give lectures on antibiotic resistance, but otherwise the authors are not in receipt of payment or support in kind for any aspect of the article; and (2) that CDM is employed as a Professor of Public Health at Bond University, has received royalties for books on unrelated subjects, has received payment from McMaster University for editing on ACP Journal Club, and that his institution has received payment for the development of educational materials on unrelated topics and funding from the NHMRC for other research projects, but otherwise the authors do not have other financial relationships with any entities that have an interest related to the submitted work; (3) that the authors/spouses/children have no financial relationships with entities that have an interest in the content of the article; and (4) that there are no other relationships or activities that could be perceived as having influenced, or giving the appearance of potentially influencing, what was written in the submitted work.
References
- Müller B, Becker KL, Schächinger H, Rickenbacher PR, Huber PR, Zimmerli W, et al. Calcitonin precursors are reliable markers of sepsis in a medical intensive care unit. Critical Care Medicine 2000;28(4):977–83.
- Baines PB, Thomson APJ, Fraser WD, Hart CA. Hypocalcaemia in severe meningococcal infections. Archives of Disease in Childhood2000;83:510–13. DOI: 10.1136/adc.83.6.510
- Van den Bruel A, Haj‐Hassan T, Thompson M, Buntinx F, Mant D. Diagnostic value of clinical features at presentation to identify serious infection in children in developed countries: a systematic review. The Lancet2010;375(9717):834–845. DOI: 10.1016/S0140‐6736(09)62000‐6
- Schuetz P, Müller B, Christ‐Crain M, Stolz D, Tamm M, Bouadma L, et al. Procalcitonin to initiate or discontinue antibiotics in acute respiratory tract infections. Cochrane Database of Systematic Reviews2012;(9):CD007498. DOI: 10.1002/14651858.CD007498.pub2
- Aronsson B, Boscan IS, Cars O, Giamarellou H, Gyssens IC, Lutsar I, et al. The bacterial challenge: time to react. European Centre for Disease Prevention and Control and European Medicines Agency joint report. 2009http://www.ema.europa.eu/pdfs/human/antimicrobial_resistance/EMEA‐576176‐2009.pdf